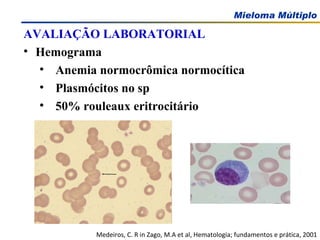
AVALIAÇÃO LABORATORIAL Hemograma Anemia normocrômica normocítica Plasmócitos no sp 50% rouleaux eritrocitário Medeiros, C. R in Zago, M.A et al, Hematologia; fundamentos e prática, 2001

Este documento discute as plasmocitopatias, doenças relacionadas aos plasmócitos, incluindo o mieloma múltiplo. Apresenta detalhes sobre a epidemiologia, manifestações clínicas, diagnóstico e patogênese do mieloma múltiplo, focando na proliferação neoplásica dos plasmócitos e seus efeitos na medula óssea e esqueleto. Também descreve exames laboratoriais importantes para o diagnóstico, como hemograma, biópsia de medula

![Obrigada Pela Atenção Vaneuza A. M. Funke [email_address]](https://image.slidesharecdn.com/plasmacitopatias-100601103420-phpapp01/85/Plasmacitopatias-91-320.jpg)